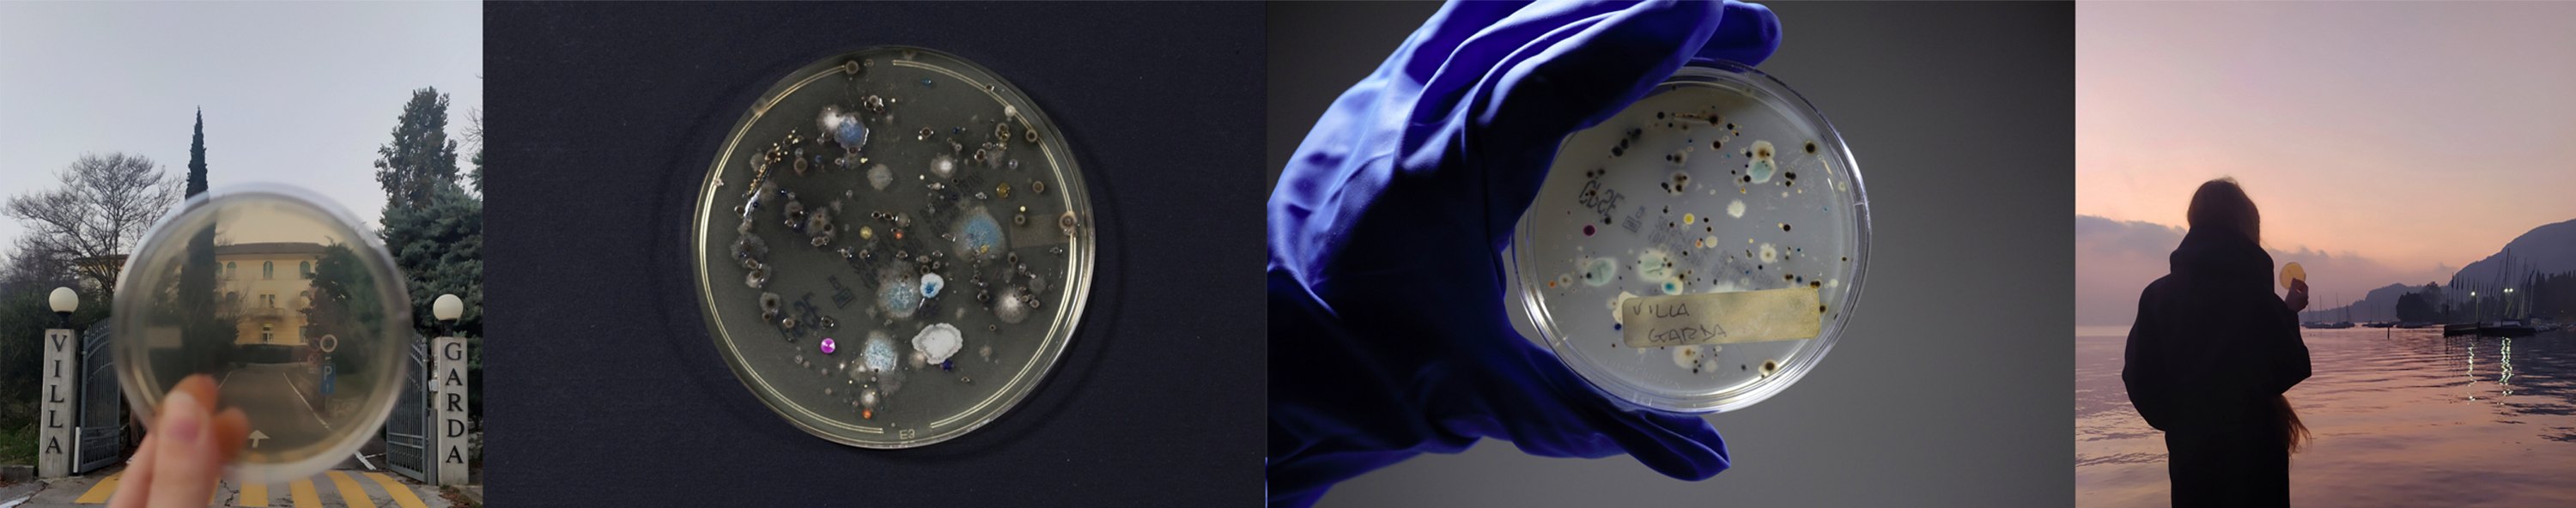
biomemory 01
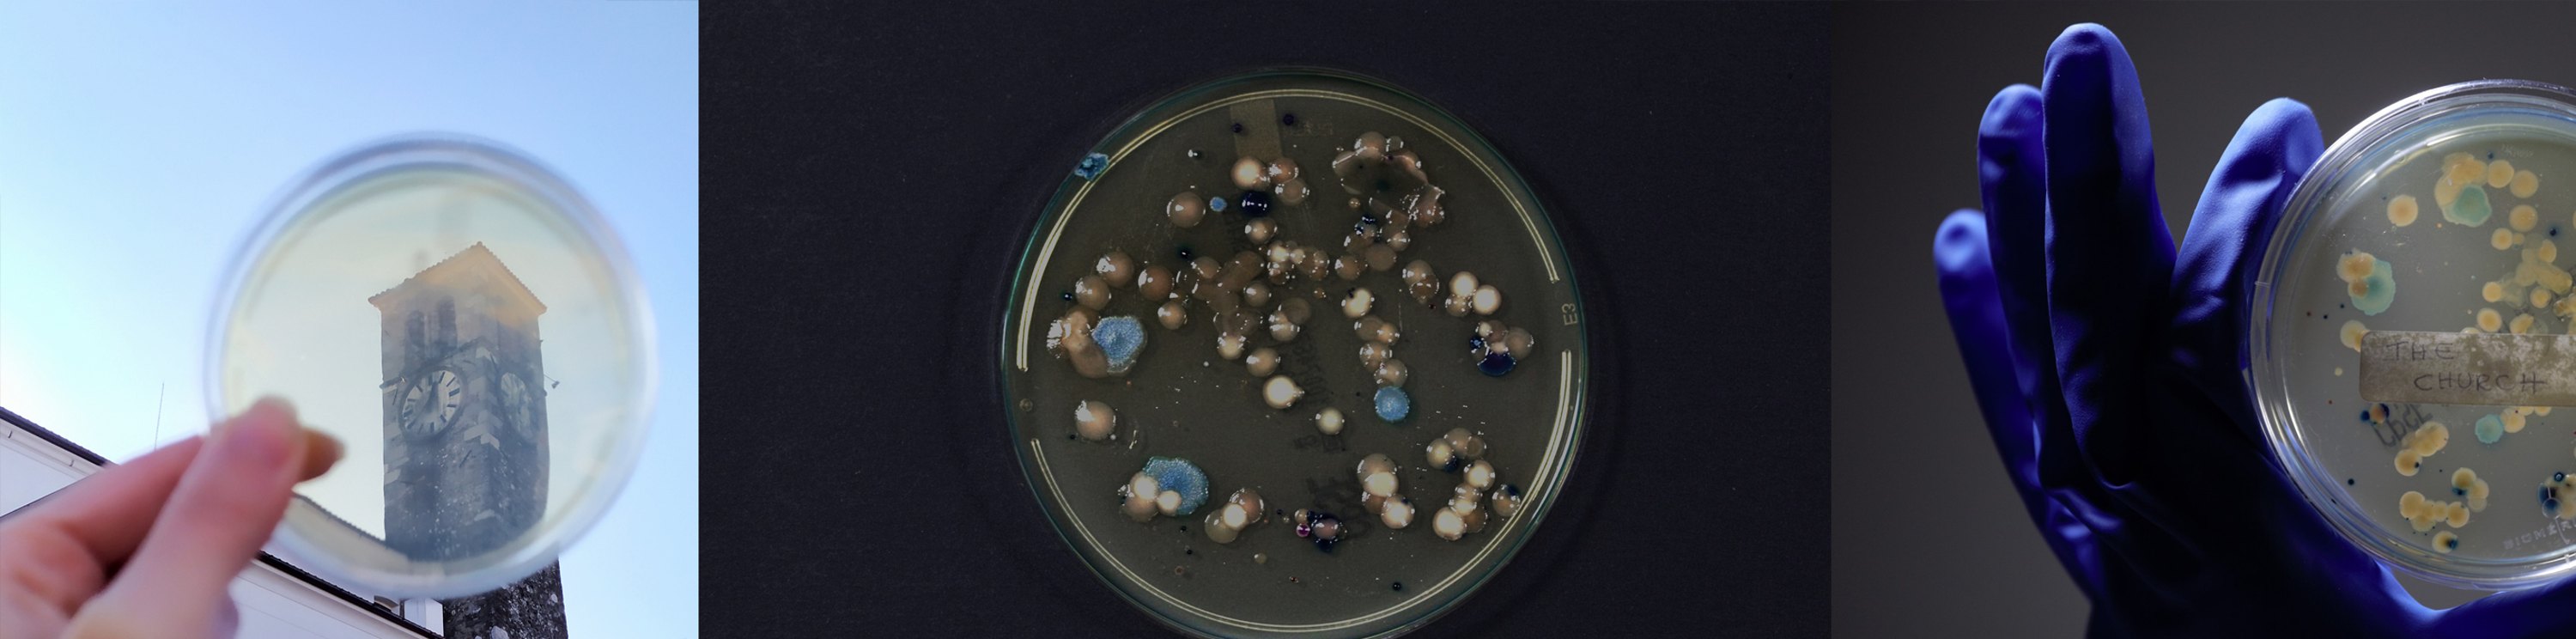
biomemory 03
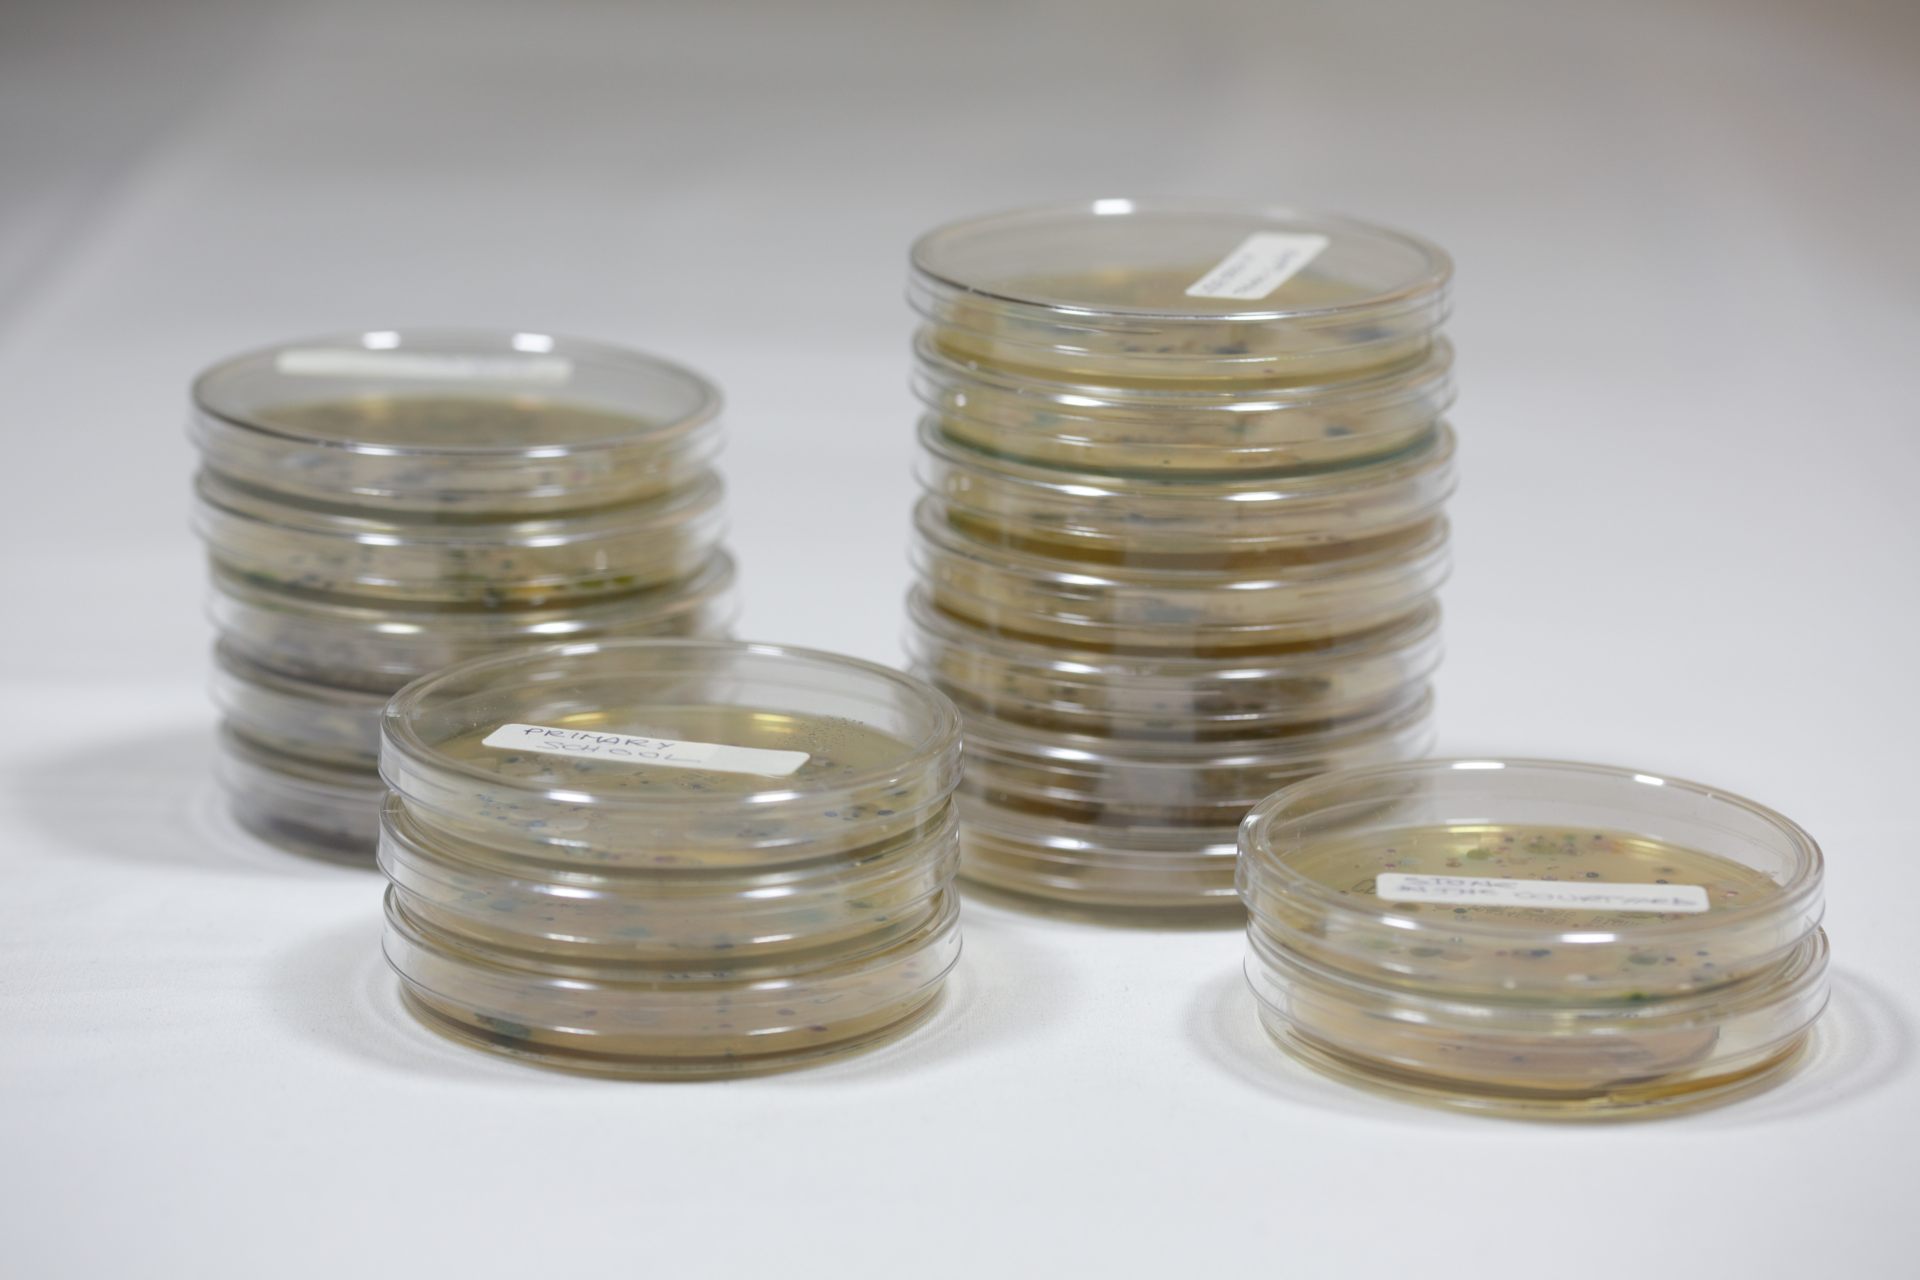
biomemory 05
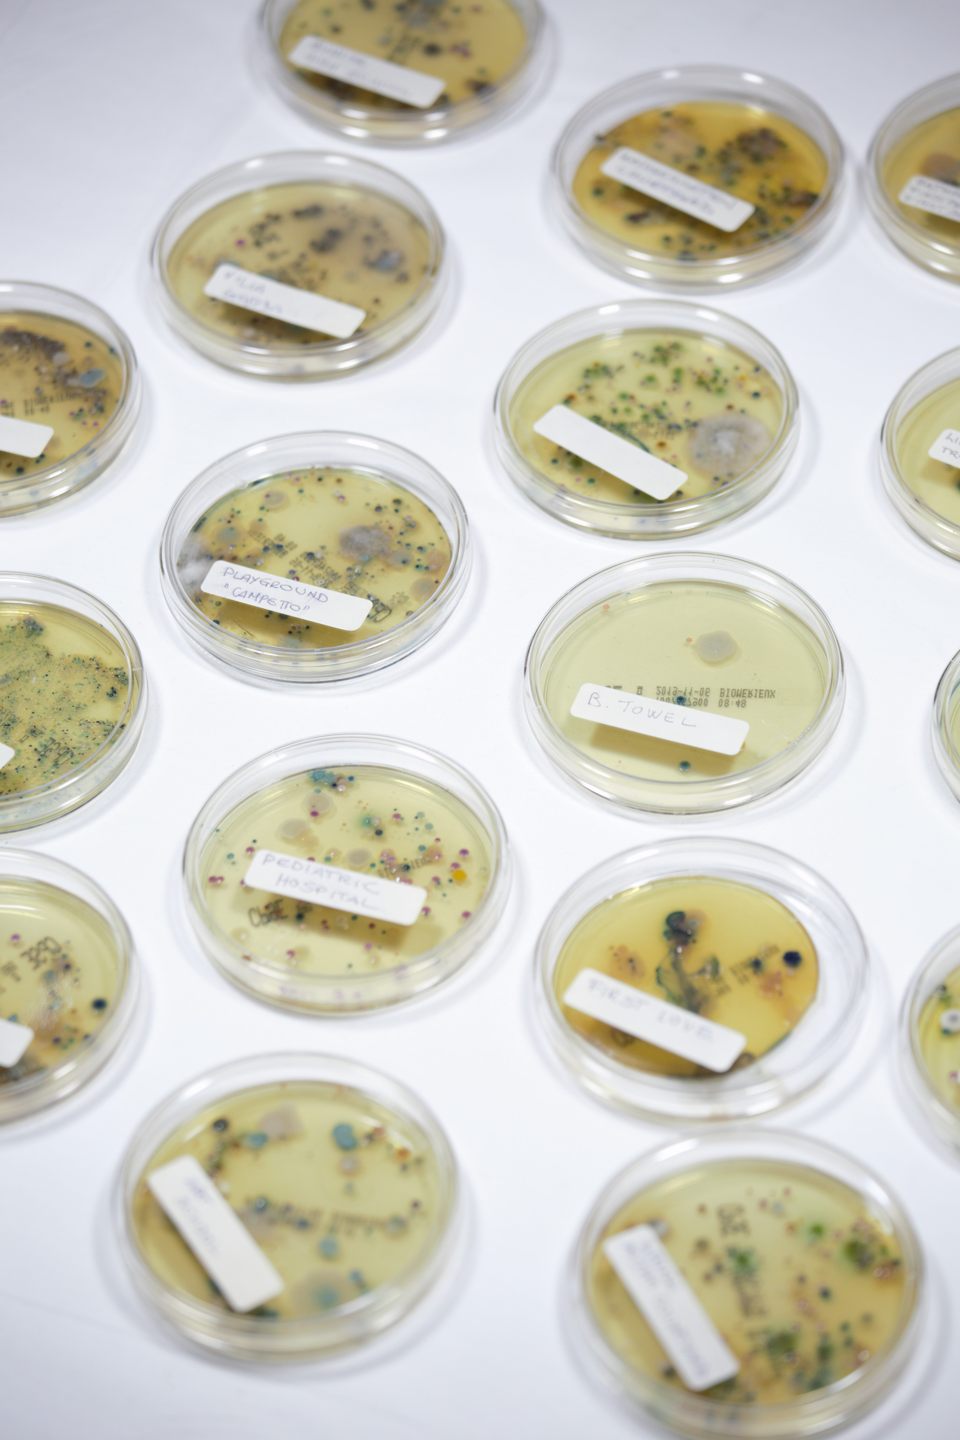
biomemory 07
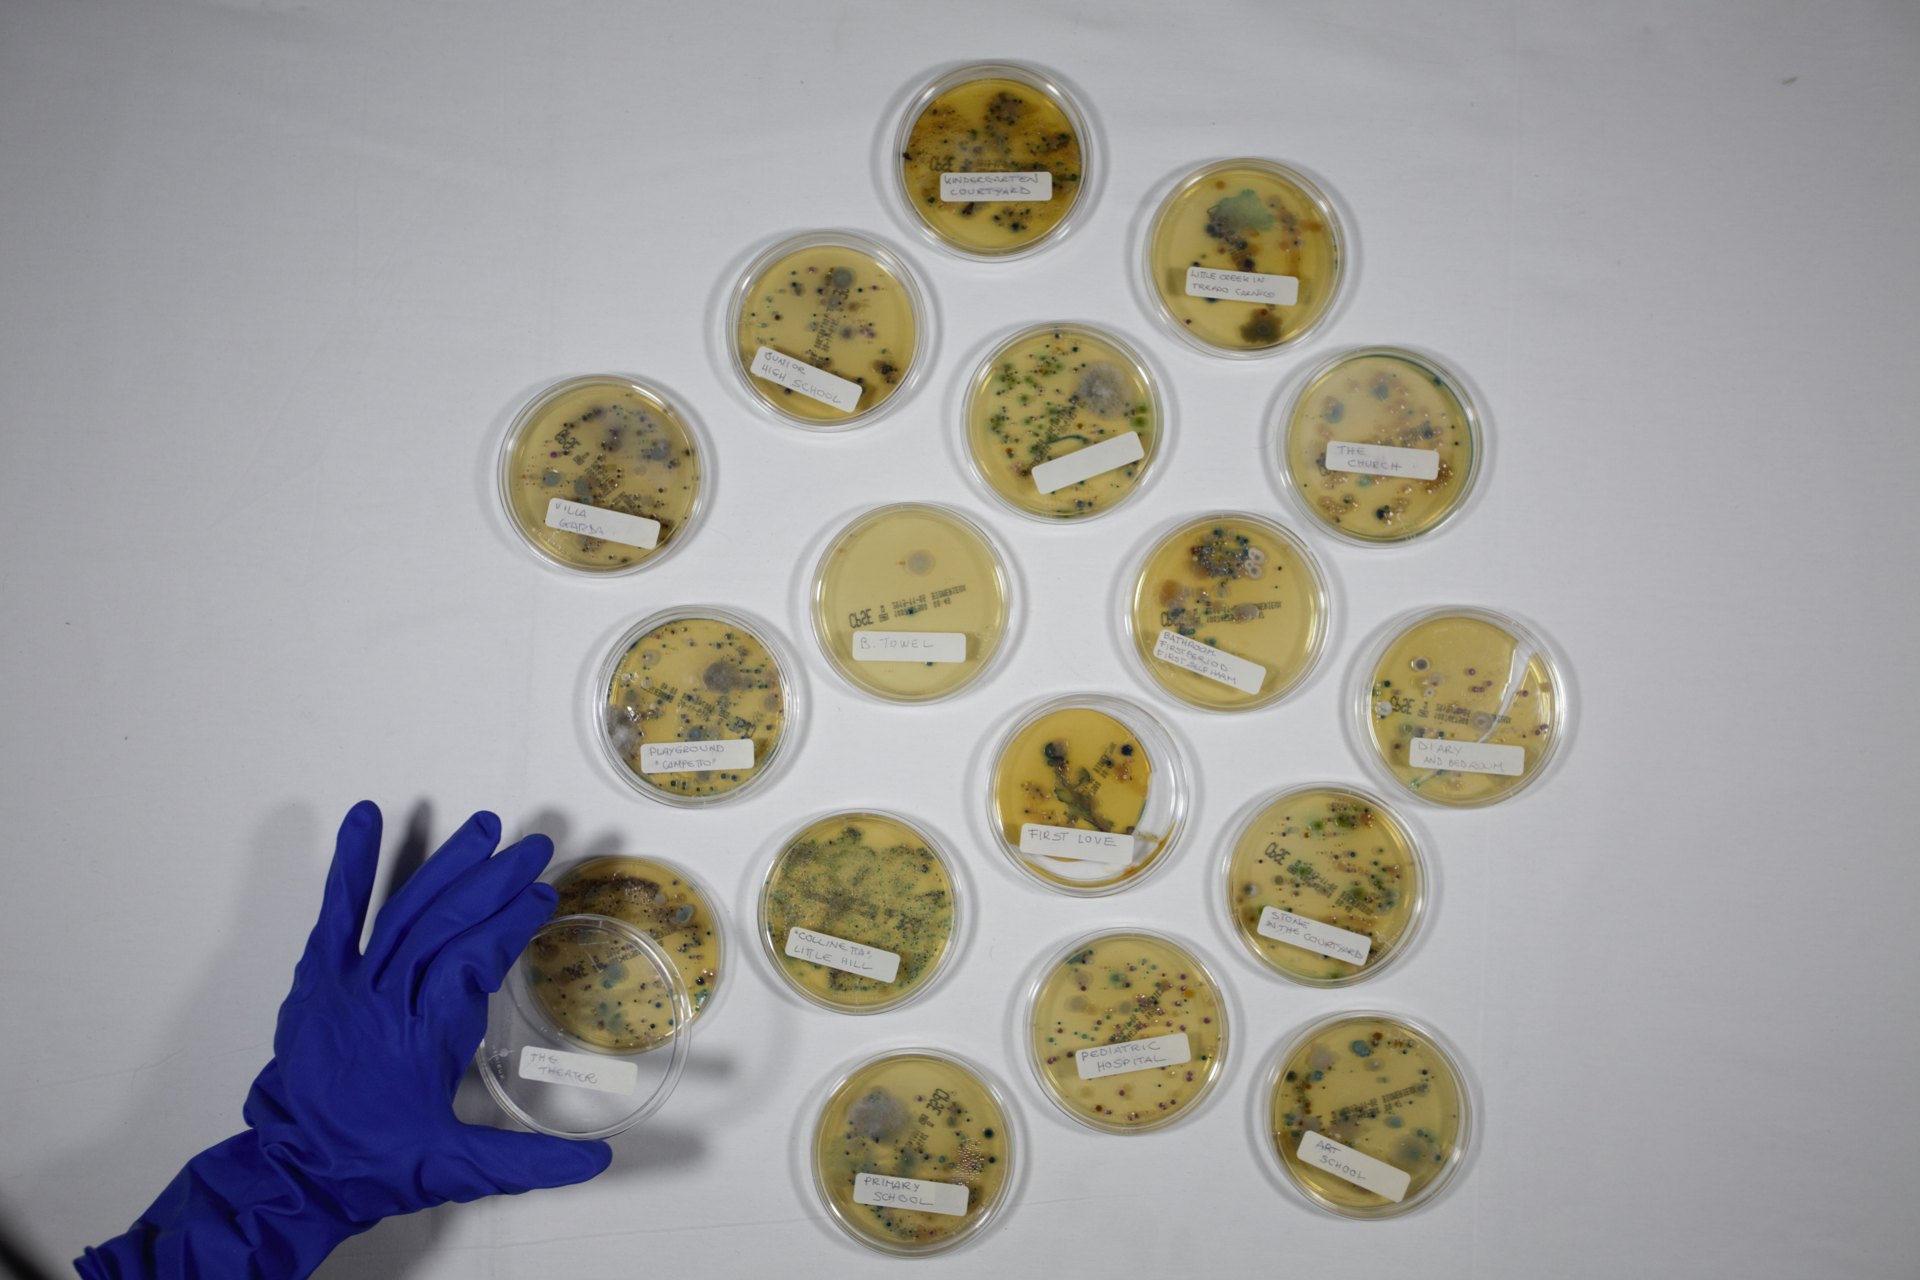
biomemory 08

Biomemories is a continuously evolving performative act that retraces biographical practices through new post-anthropocentric languages. Personal memories transcend singularity and interweave with the spirit of places and the shifting phenomena of life.
The project begins as a therapeutic journey of recovering submerged memories through the body and biographical practices of "place-based memory work” in trauma therapy directed toward healing trauma.
Memory is not simply stored in the mind, but bound to physical places that serve as anchoring points for remembrance. Returning to a place can reactivate forgotten memories because the environment preserves traces of past experiences.
The body's interactions with the surfaces of past places bring forth submerged memories and invisible microbiomes. The petri dish becomes the medium for making visible the interconnections between memories, body and places through a microbial snapshot that transcends the limits of one's own being to expand toward another, broader meaning of shared memories.
Biomemories consist of photographic compositions that alternate microbial snapshots with images of the places to which they are connected.
These images are accompanied by brief found footage video works that amplify the concept of collective memory through media images connected to that time and place.